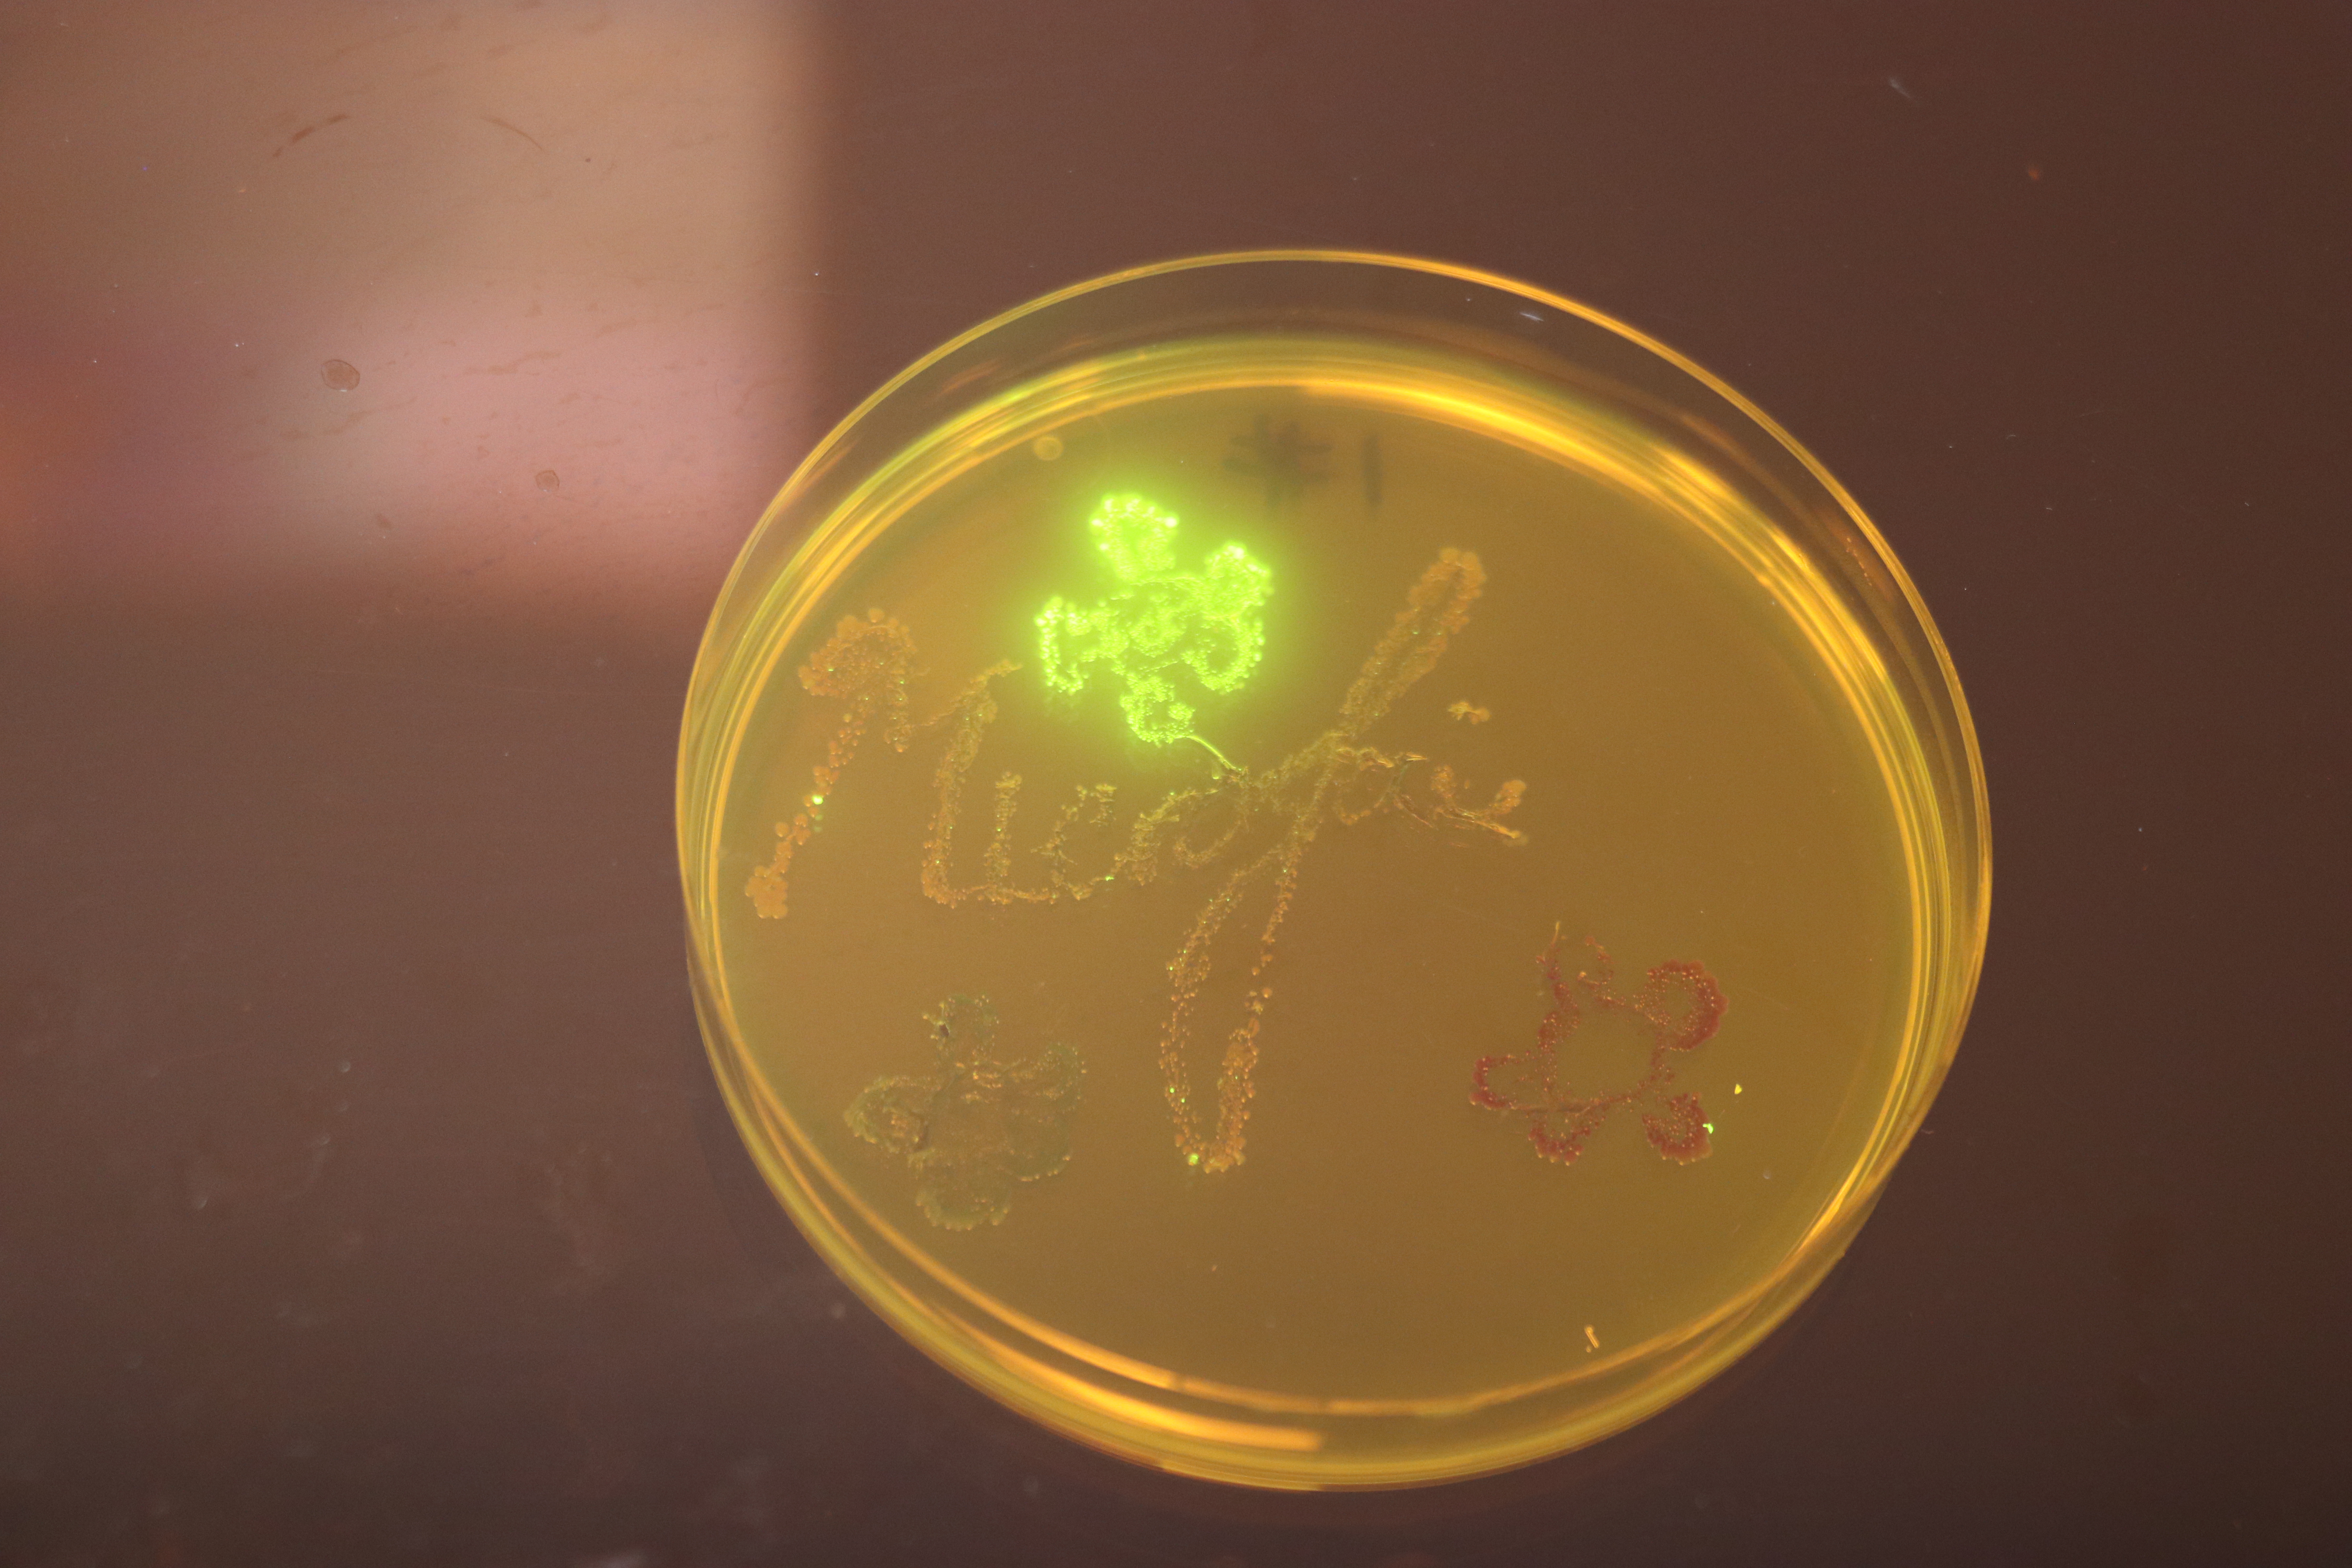
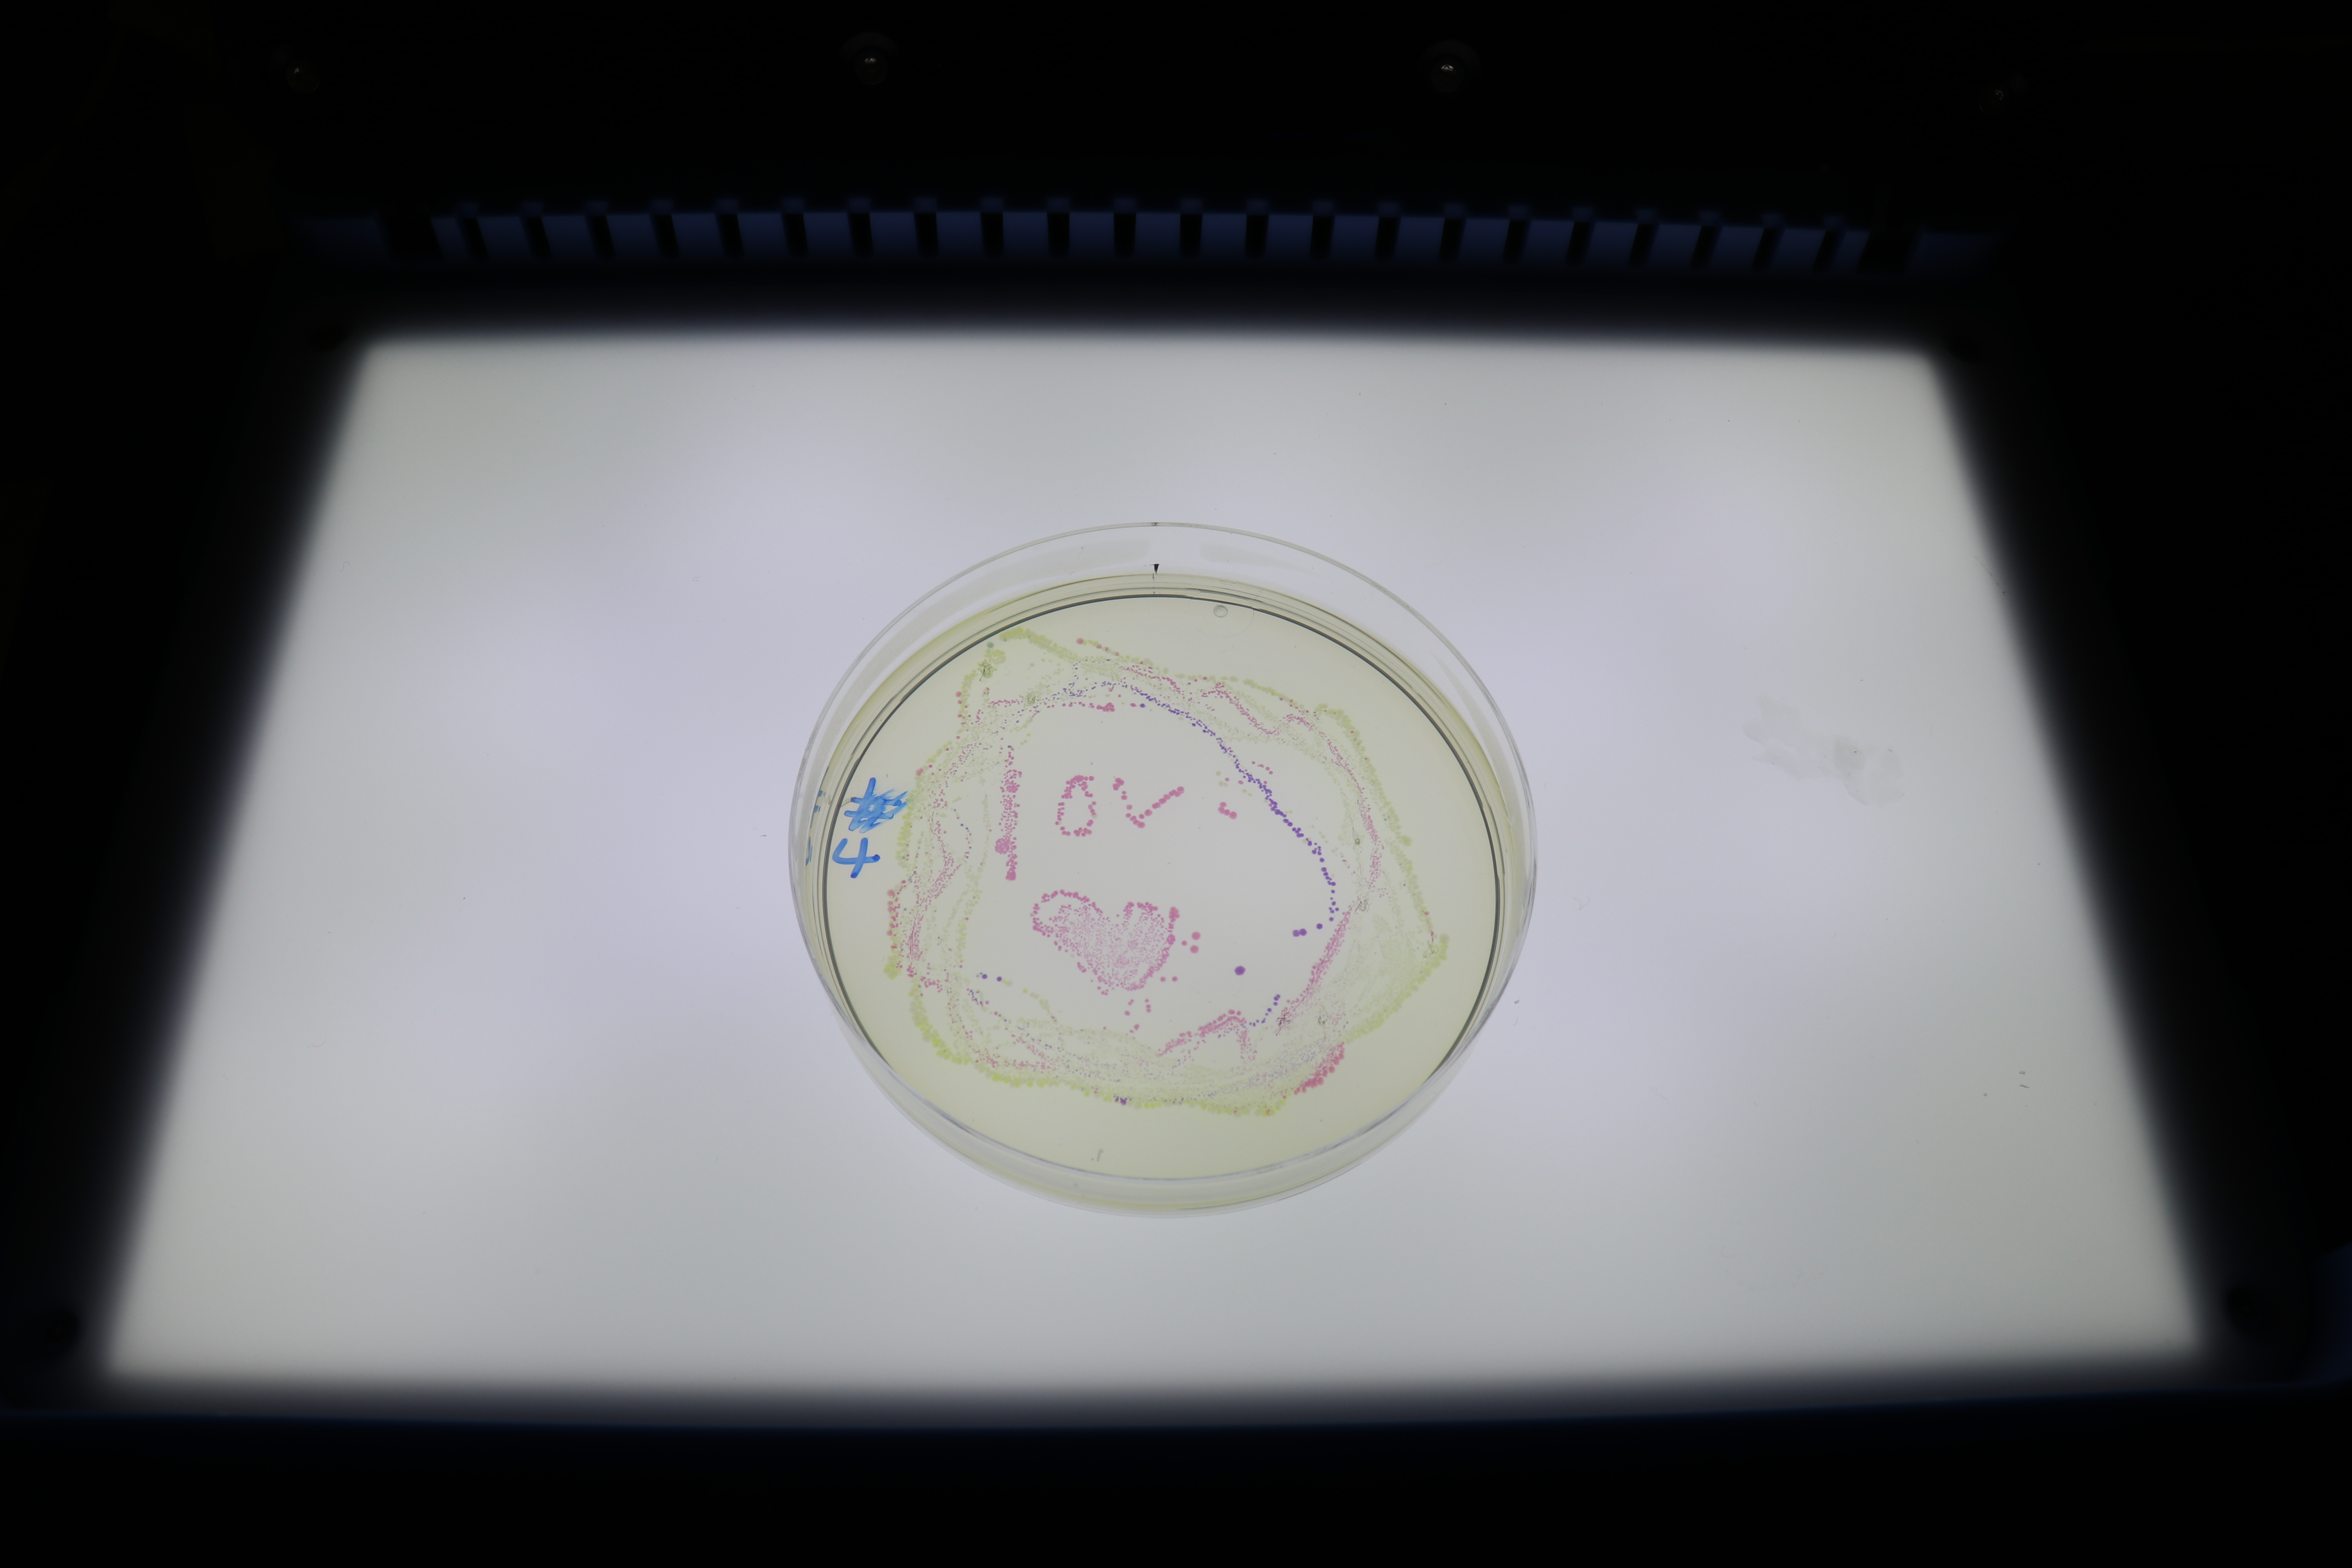
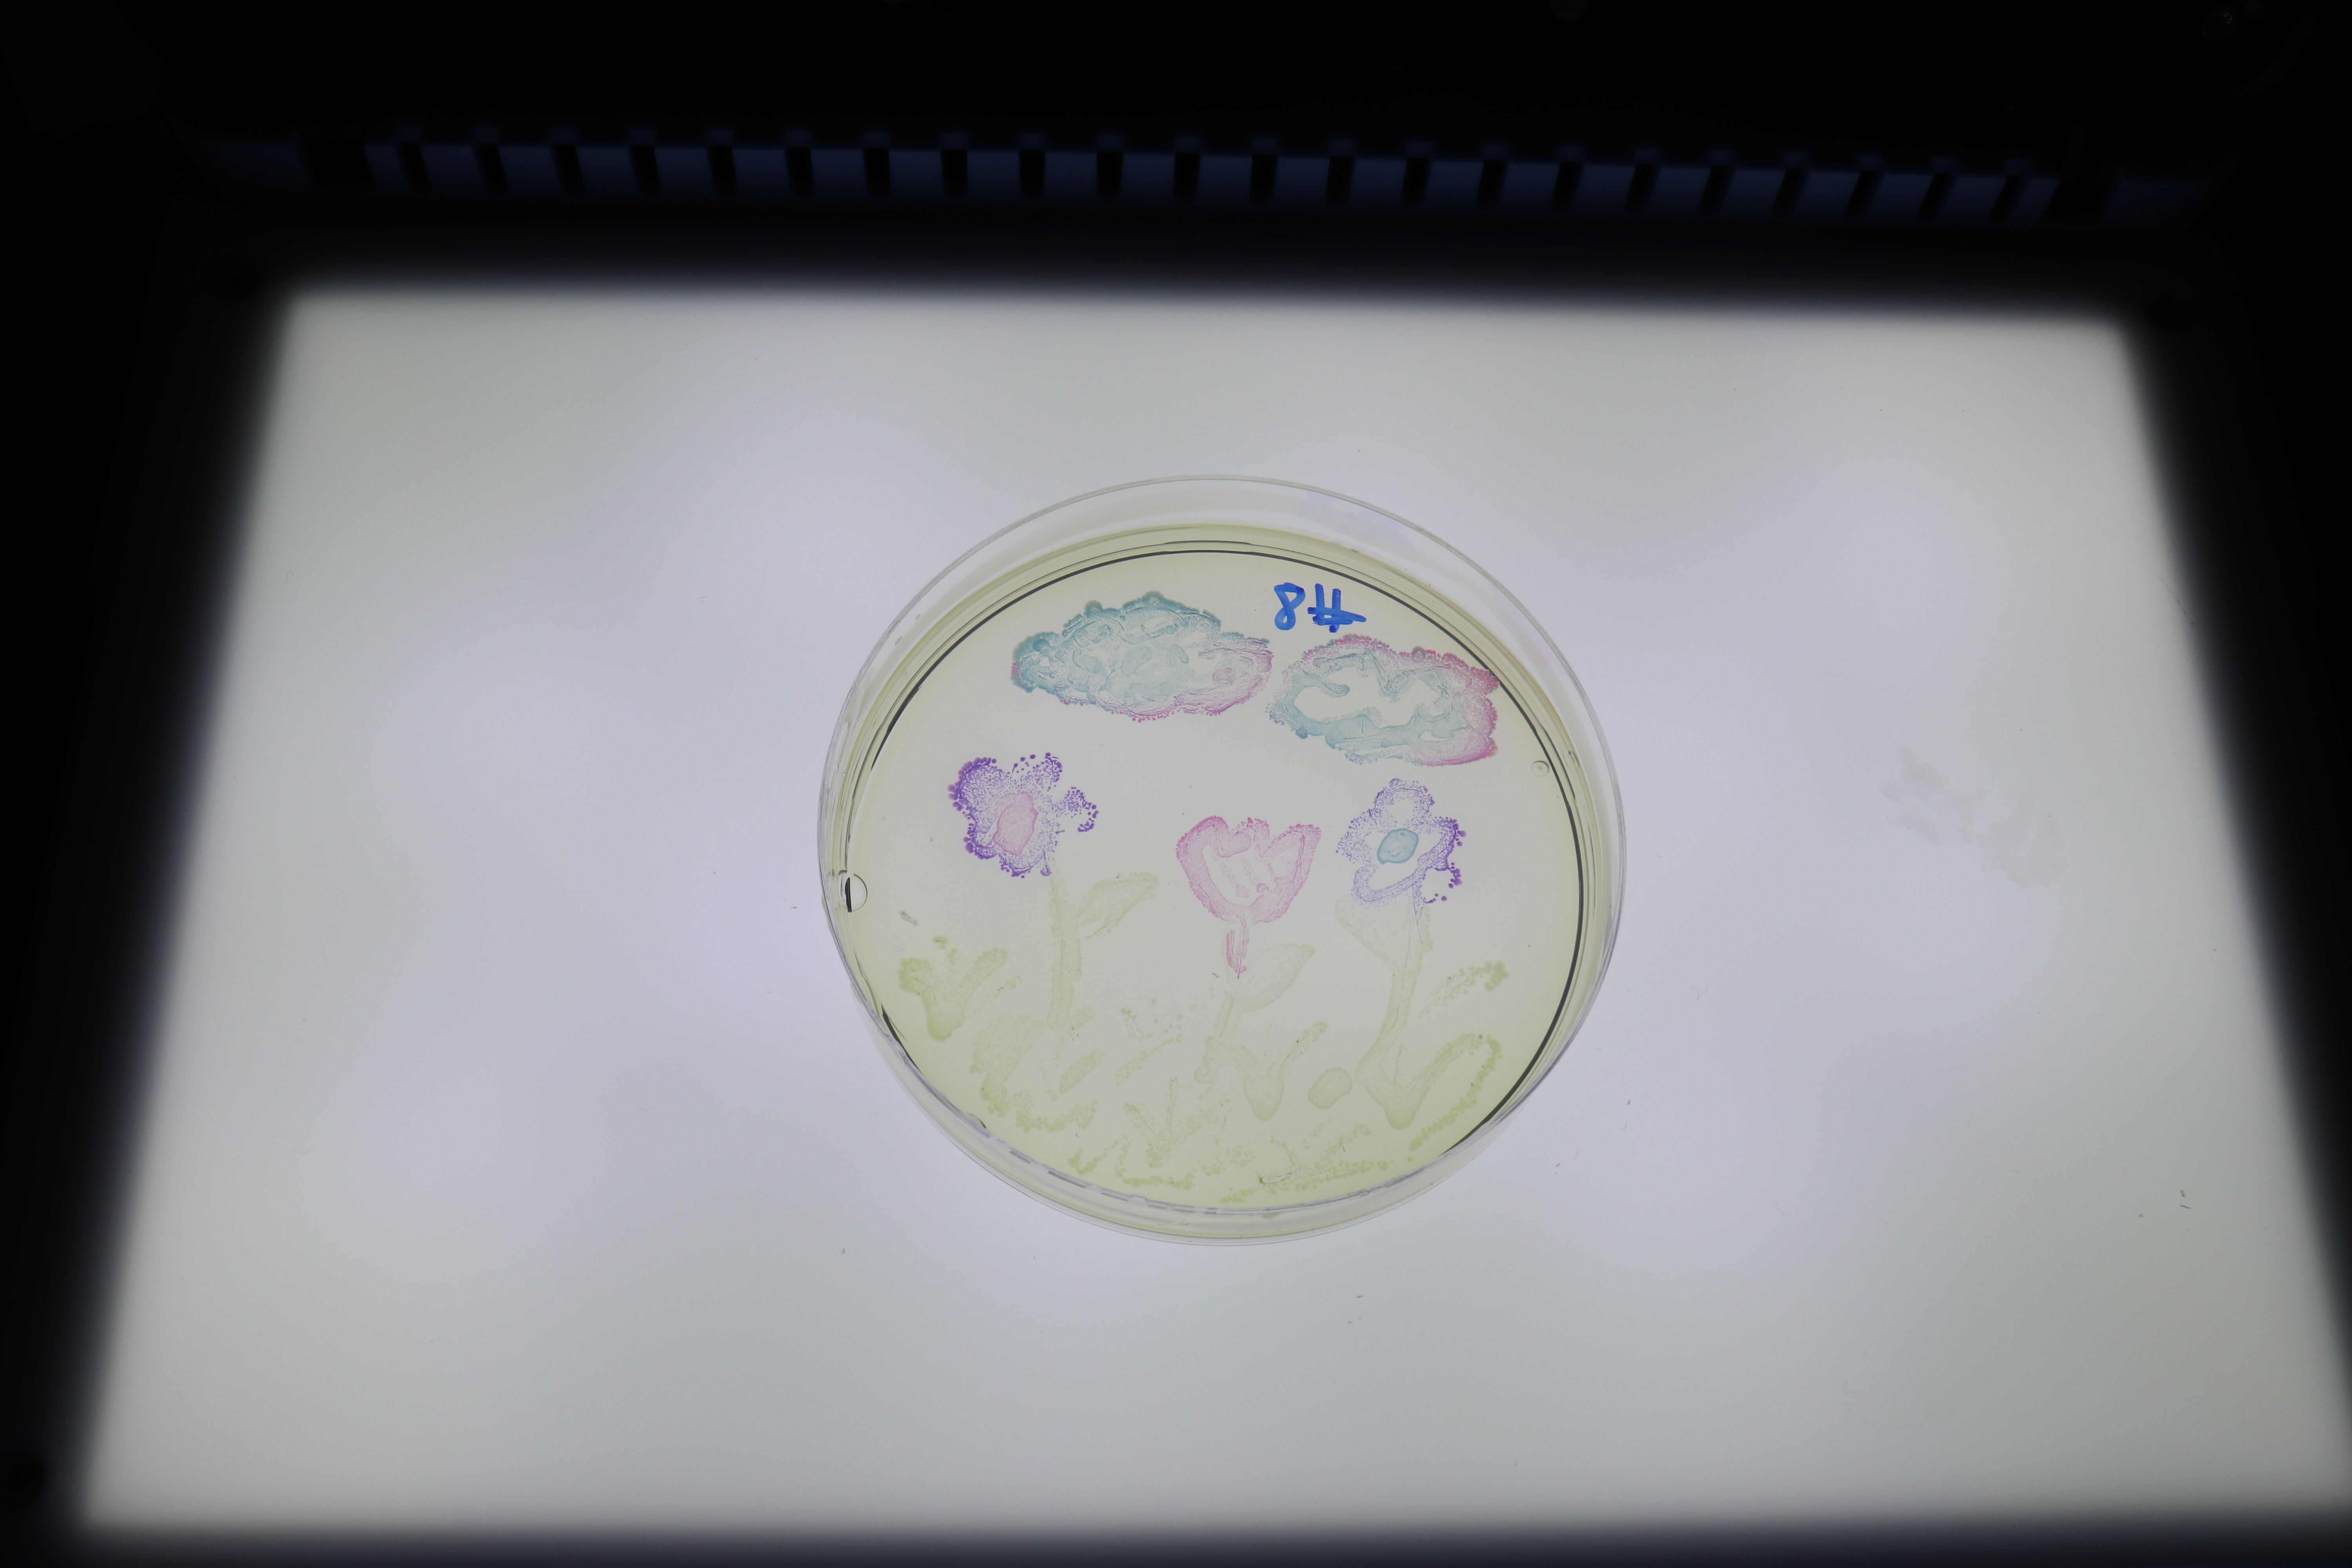
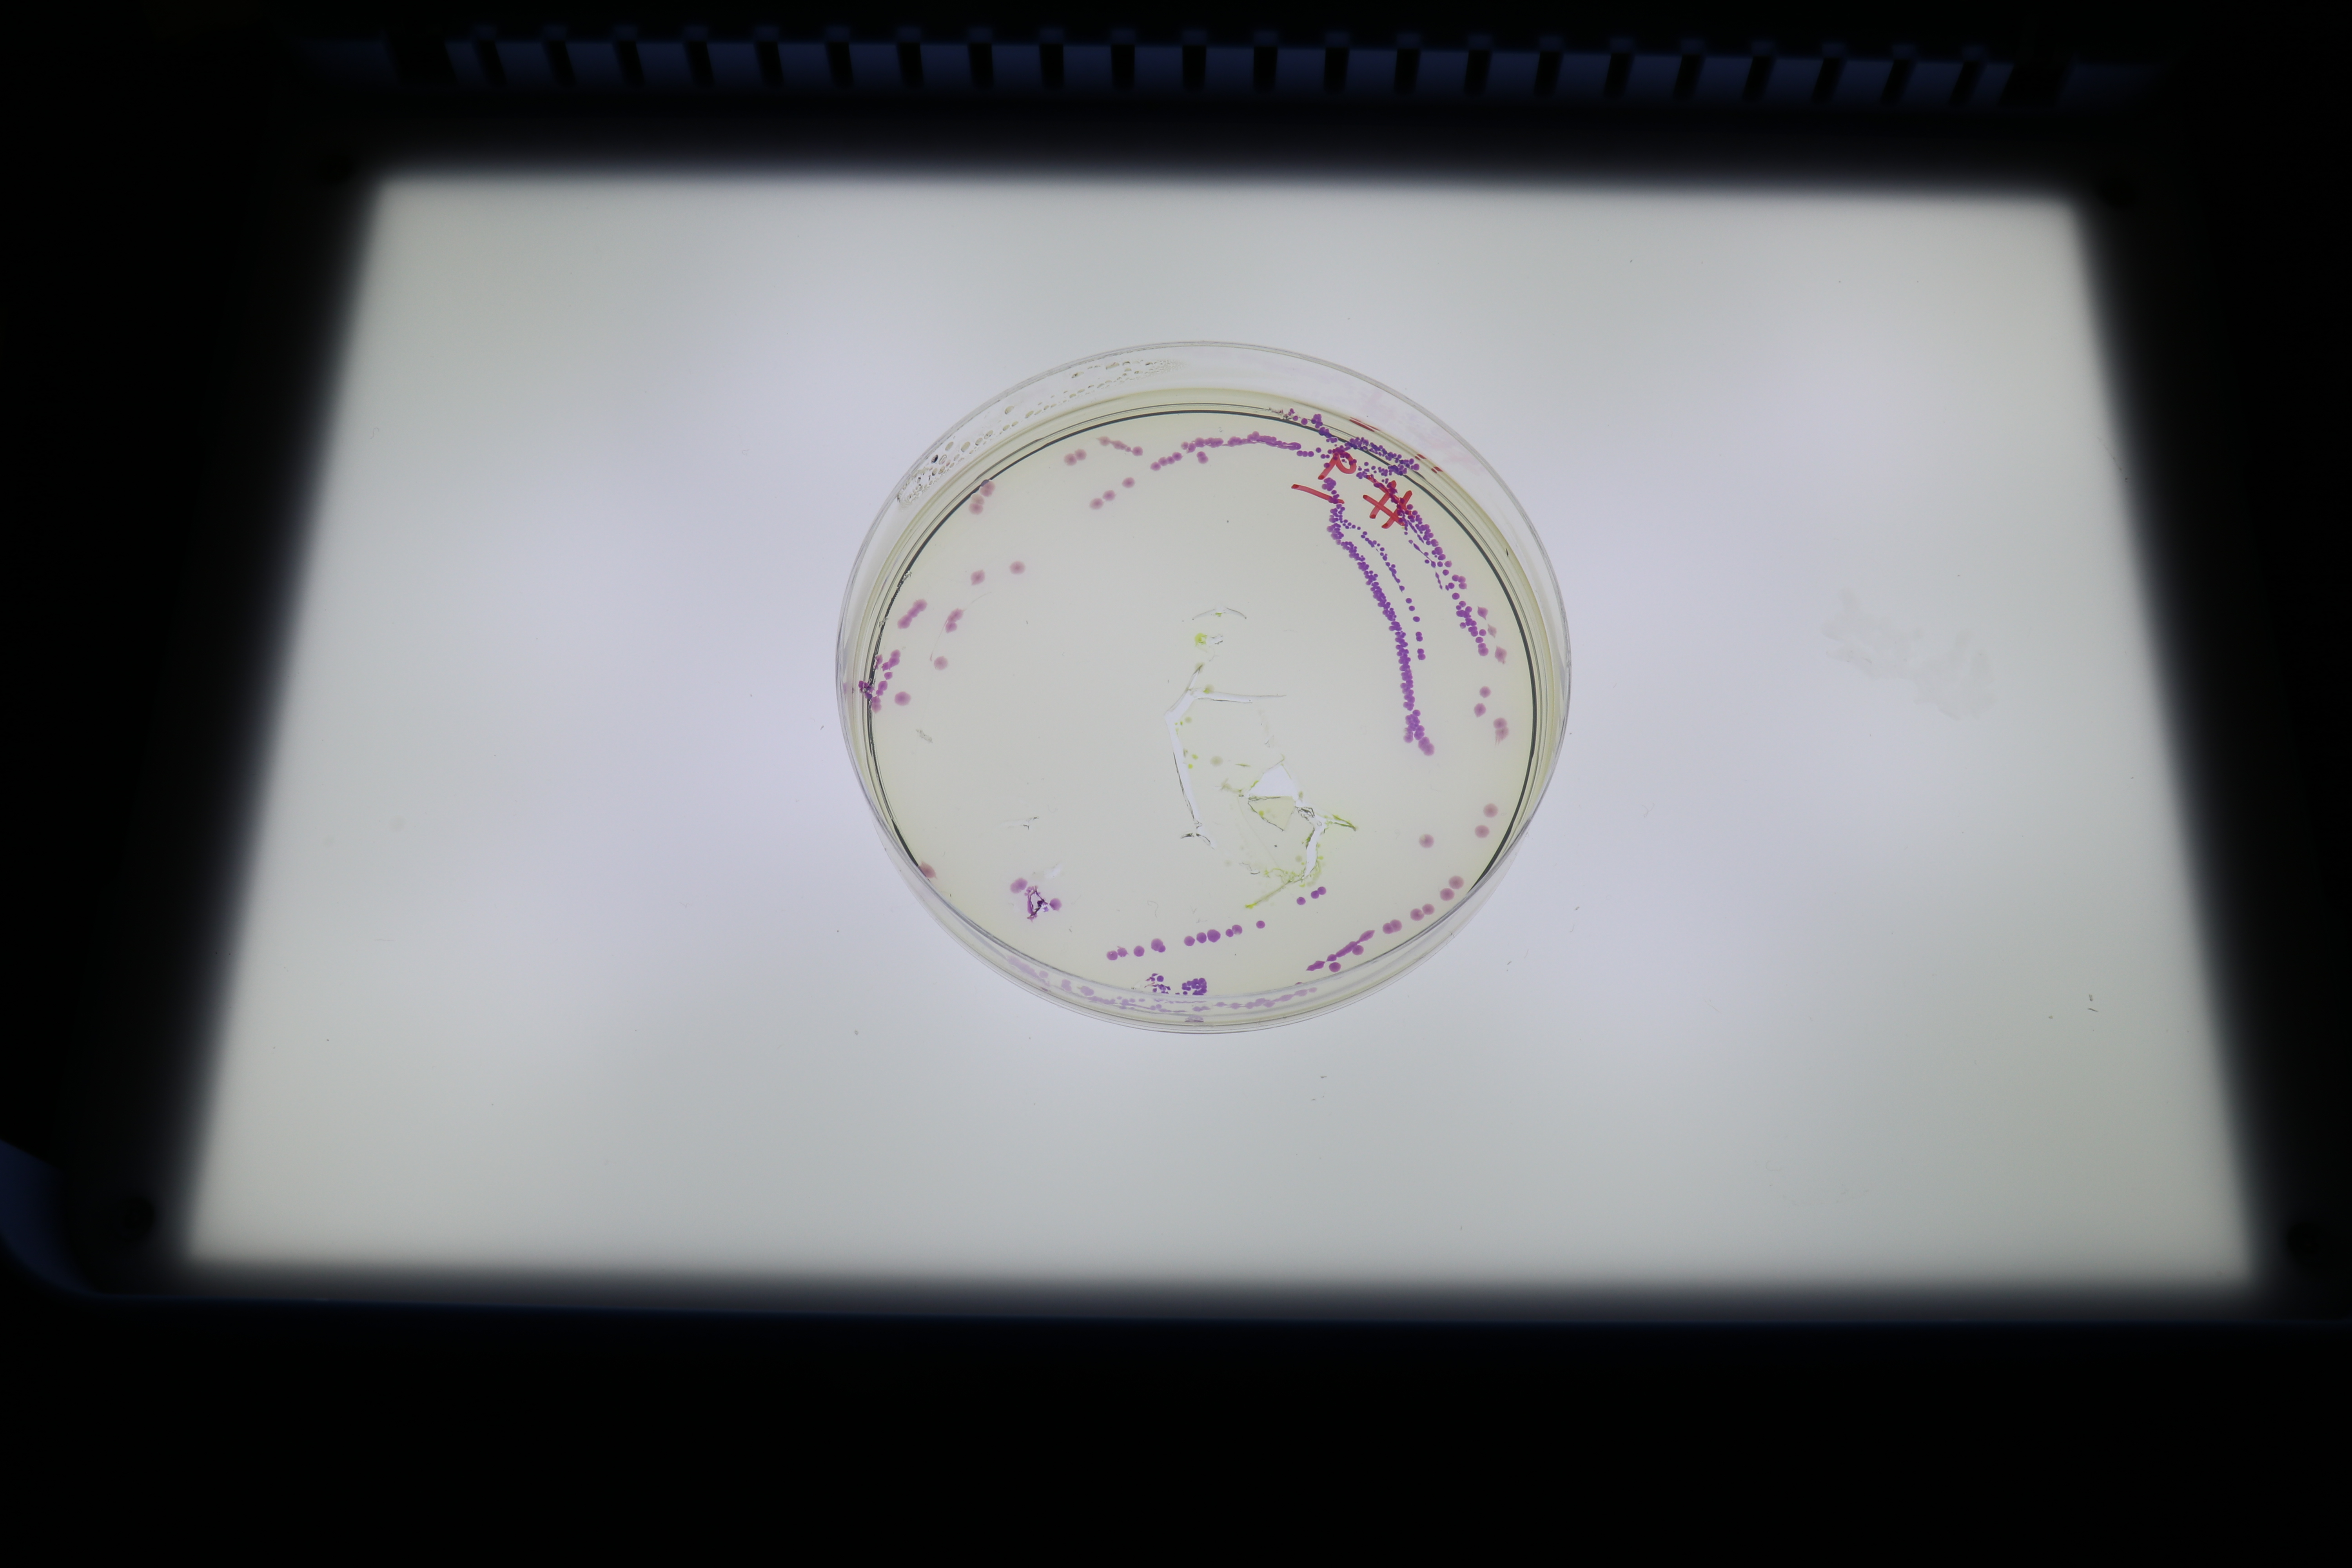
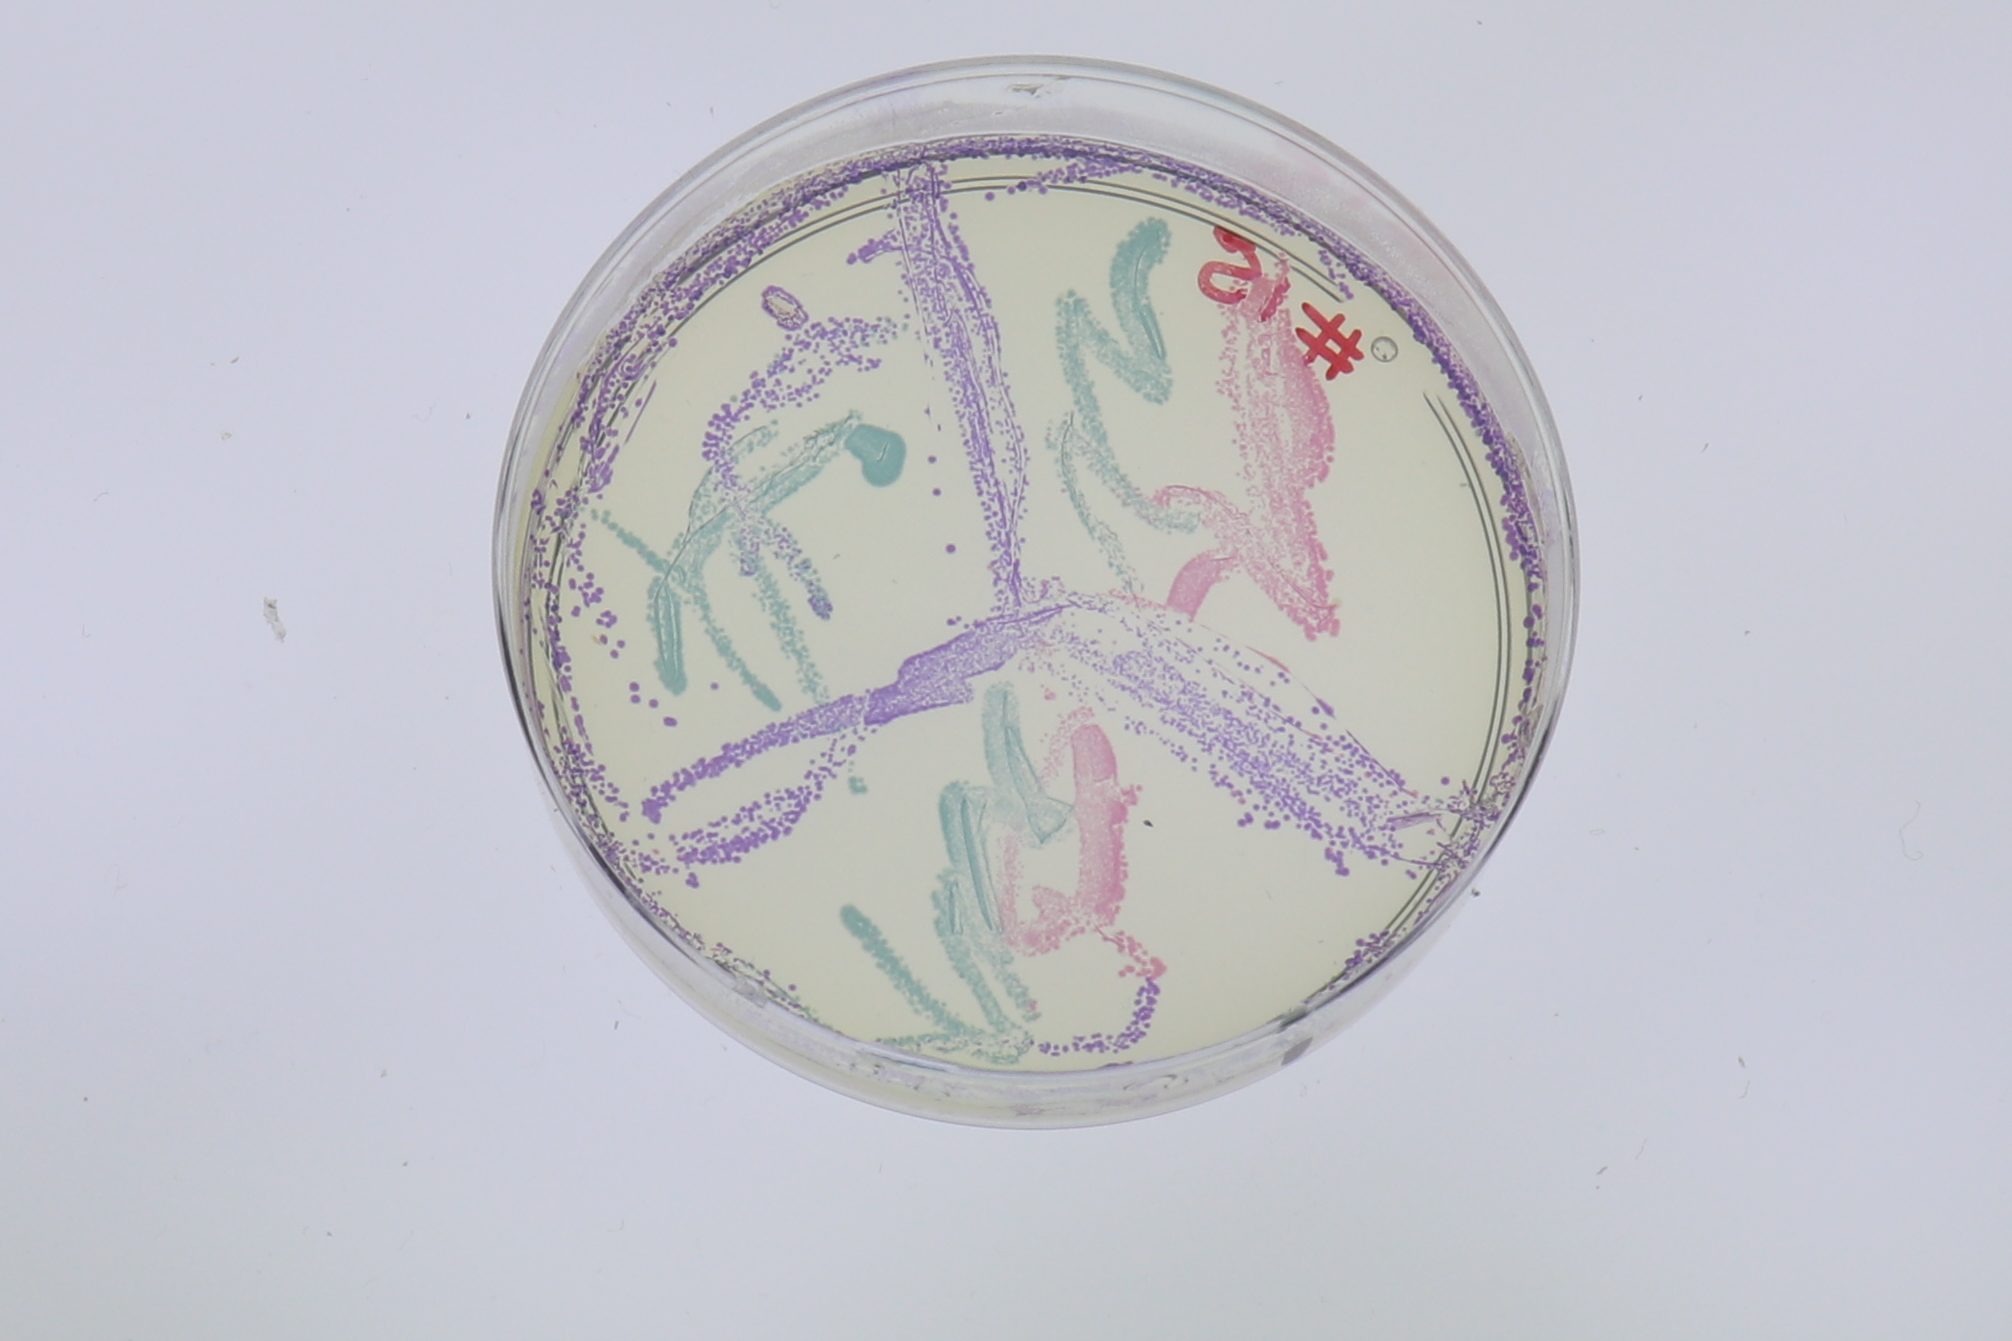
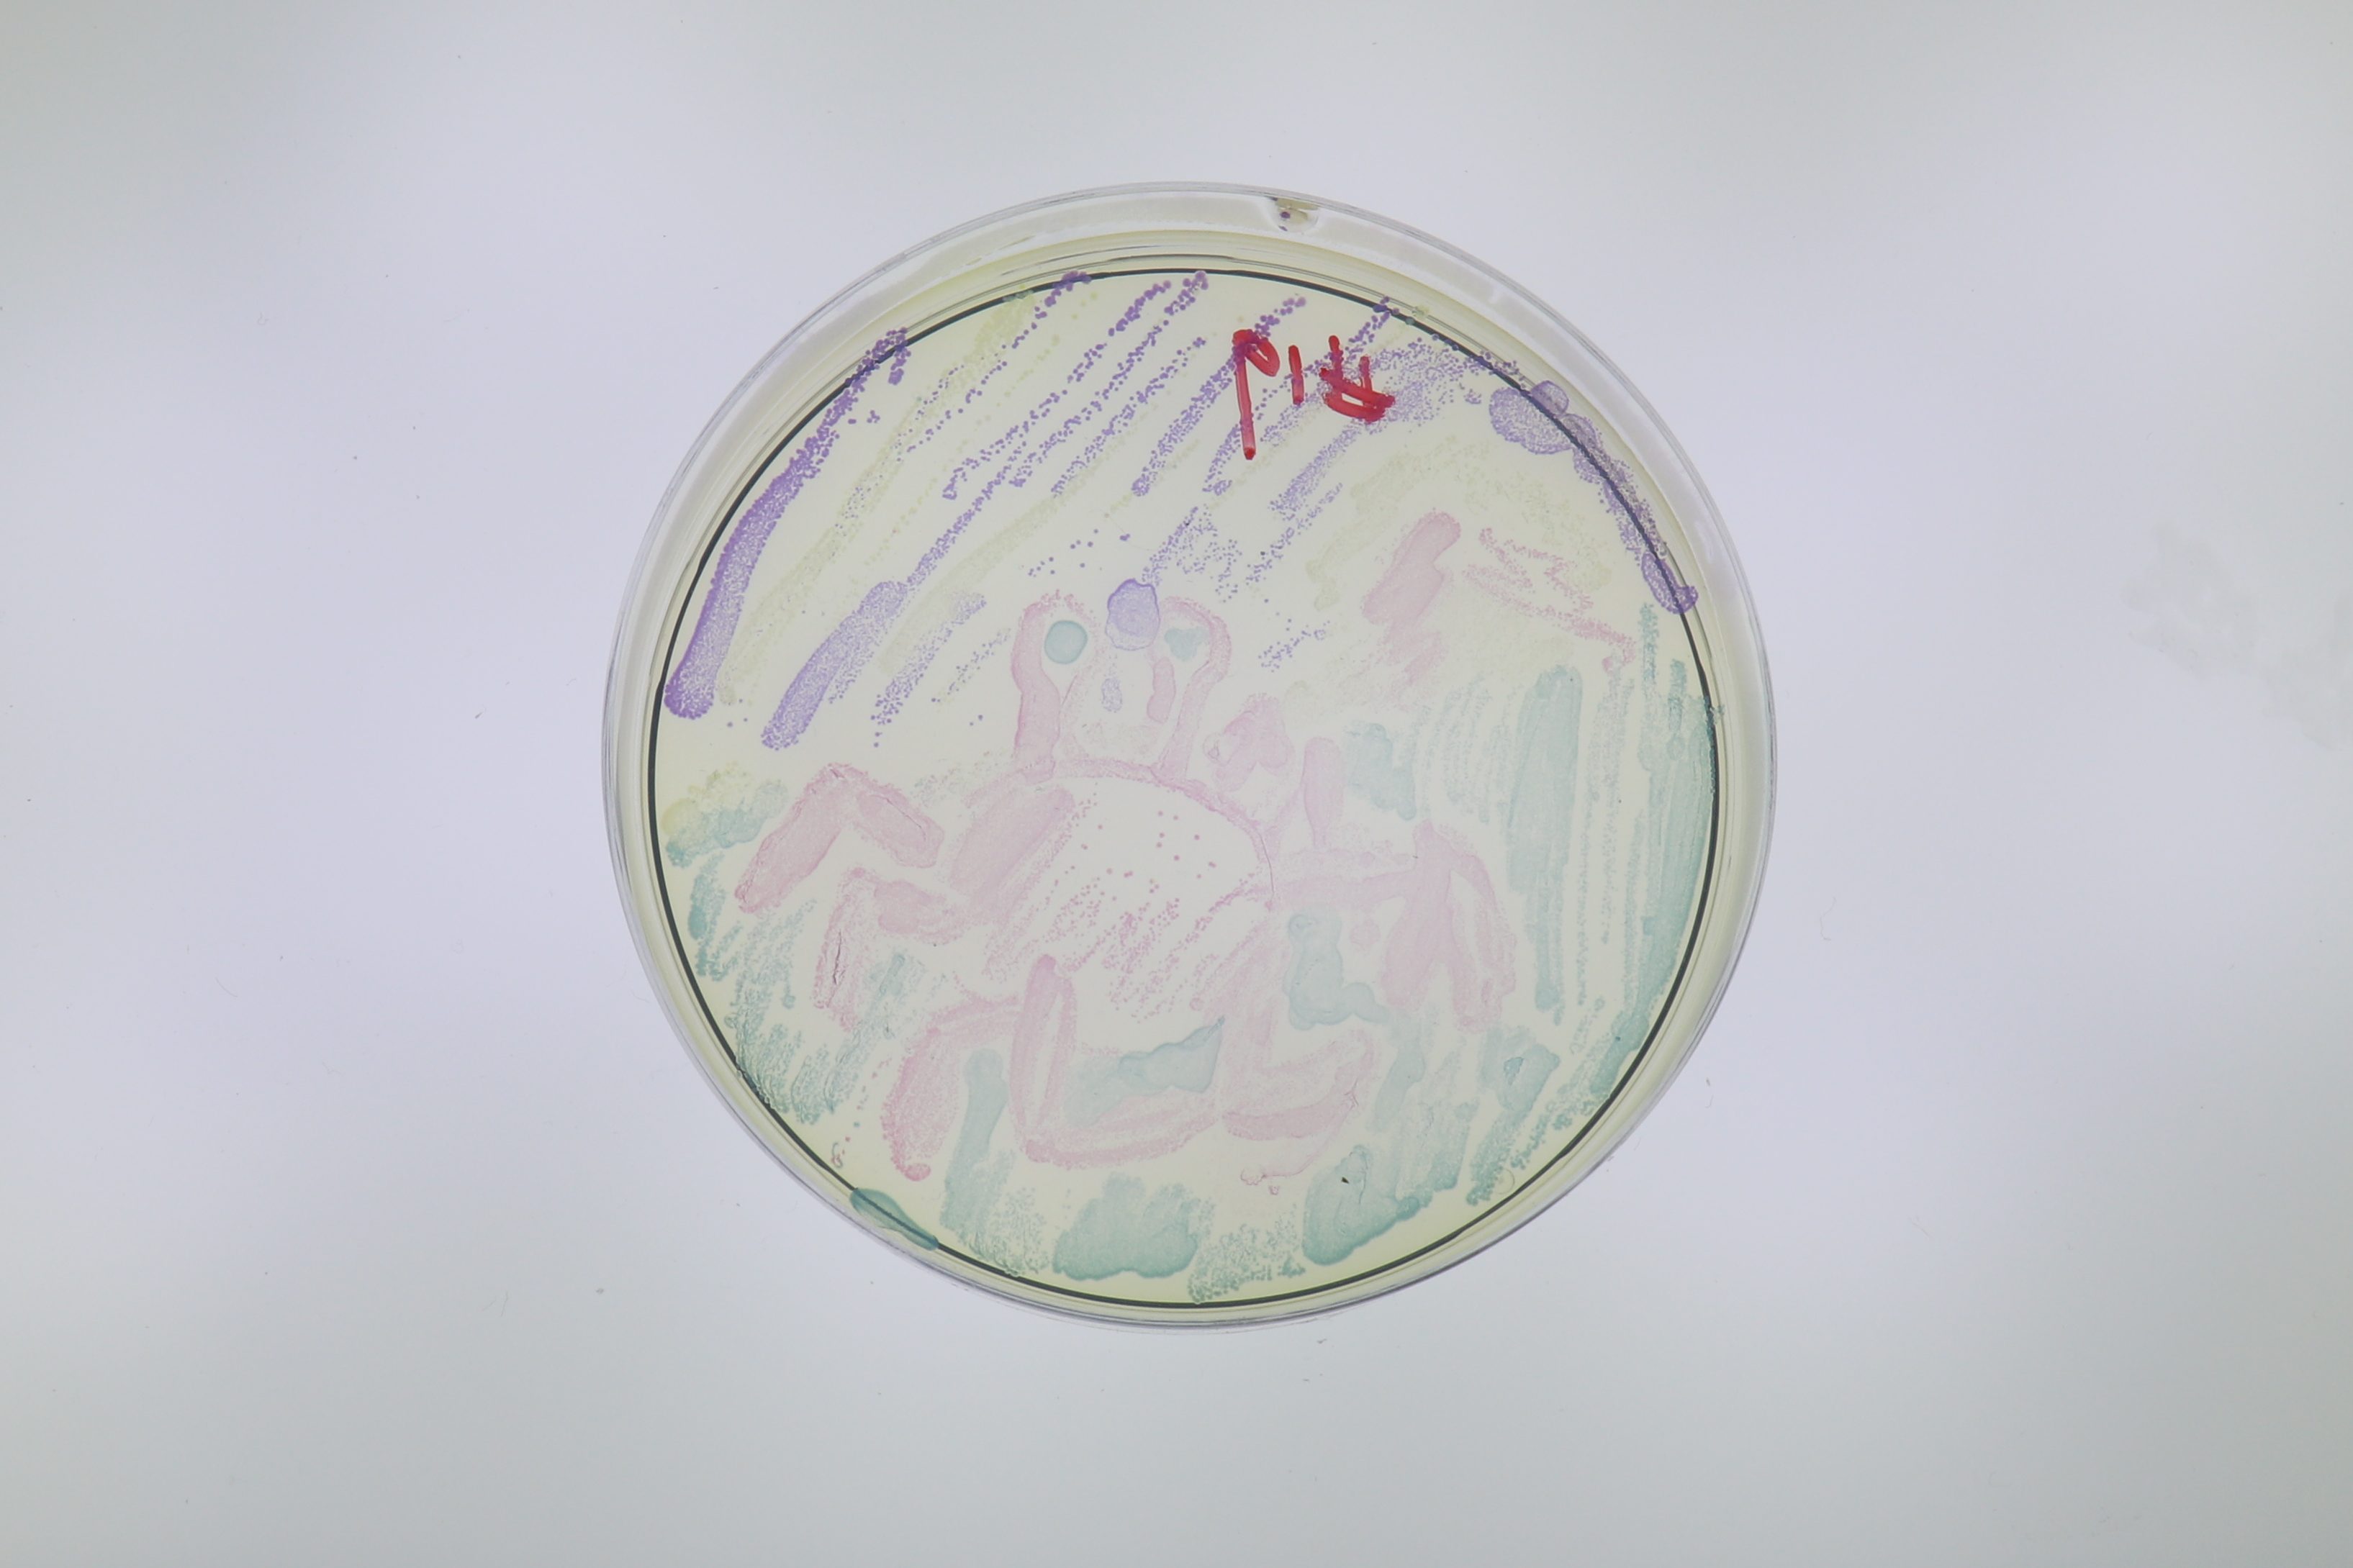

Last week, we teamed up with the American Society for Microbiology to create some Agar Art at the Petworth Neighborhood Library in Washington, DC. Agar art is a STEAM activity that uses living microbes to create living masterpieces, connecting arts to the science curriculum, encouraging out of the box thinking, and fostering a love of creativity. Plus, it helps make our microbiology lessons fun and interactive. Over thirty people joined us to create their microbial masterpieces. There were two incredible techniques demonstrated at the event: bacterial handprints and microbe painting.
The first bacterial handprint I saw was produced by Tasha Sturm, a microbiologist/lab coordinator at Cabrillo College. She first became an agar artist when she pressed her child’s hand onto an agar plate and incubated it to encourage microbial growth. The results were amazing! In fact, you may have seen this image, as it was covered on many websites, including those that cover science, education, art, and even parenting! (I suppose it is initiative to encourage good handwashing in kids!).
Attendees at the outreach event were encouraged to press their hands into the bacterial medium to capture the microbes. Some of the early results were posted to Twitter! The plates will require some more growing to encourage those microbes that need a little more time, but we can clearly see where the fingers and palms pressed into the agar. We can’t wait to see more!
The second technique demonstrated at the event featured our very own “ready to paint” BactoBeads, featured in our Agar Art Kit. It was very easy to make the bio-paints. We just added the beads to liquid LB/Amp/IPTG and incubated at 37C for thirty minutes before it was aliquoted into microcentrifuge tubes. All of our bio-paints are E. coli that have been transformed with plasmids that reprogram the bacteria into living factories that create our colorful proteins. We like this system because all of the bio-paints grow at the same rate, meaning that it’s fast and easy to get art with crisp lines and bright colors.
At the event, attendees were each assigned a number on their agar art “canvas” – that is, their petri plate. They then used loops to transfer the bacteria to the surface, much like we would do with paint and a paintbrush. The “canvases” were brought back to Edvotek’s DC headquarters and incubated overnight at 37C. After they were done incubating, we removed them and took pictures. Below, you’ll find our amazing agar art! Congratulations to all of the artists for creating such fun and wonderful works of art. We are in awe of your imagination! Please note: all images have assigned numbers. If you painted a plate at the event, we will contact you with a reminder about your number. We did not use names here to protect the privacy of our awesome kid scientists.
Thank you to all our amazing artists for showing up and sharing your talents with us! We can’t wait to see what you create in the future!

2 comments
Comments are closed.